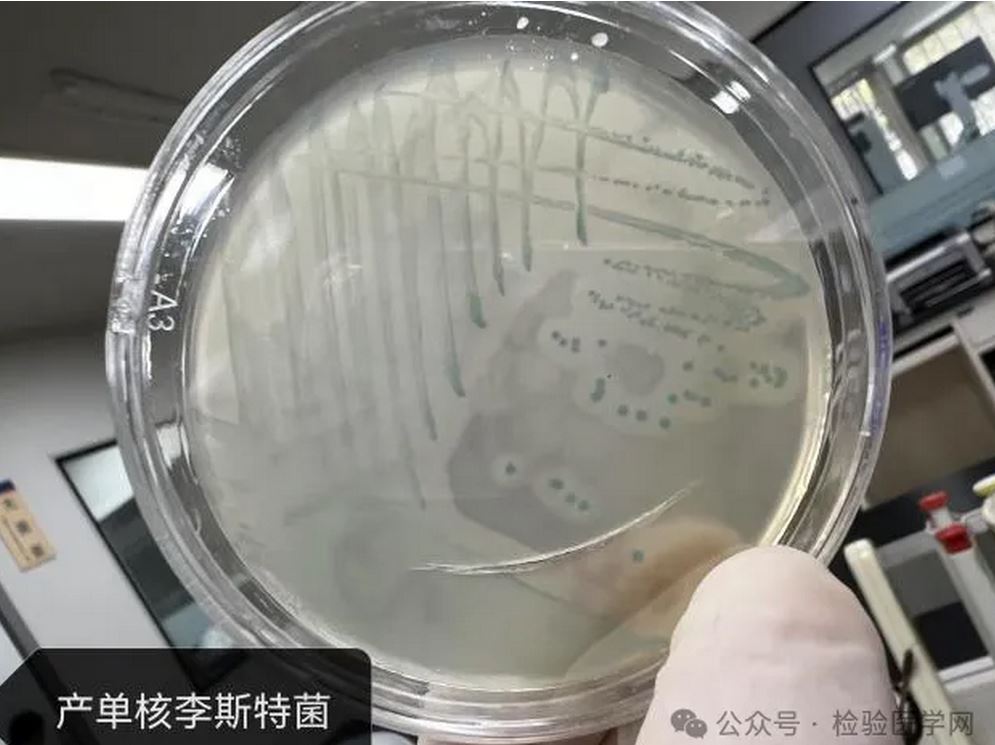

产单核李斯特菌实验室检测过程分享
作者:王雪岩,承德市中心医院检验科
产单核李斯特菌(Listeria monocytogenes)属于李斯特菌属 ,是一种革兰阳性小杆菌,能在低温环境下生存和繁殖,主要以食物为传染媒介,肉类、蛋类、禽类、海产品、乳制品、蔬菜等都可能是李斯特菌的感染源,因此其也被称为“冰箱杀手”。
,是一种革兰阳性小杆菌,能在低温环境下生存和繁殖,主要以食物为传染媒介,肉类、蛋类、禽类、海产品、乳制品、蔬菜等都可能是李斯特菌的感染源,因此其也被称为“冰箱杀手”。
该菌需氧或兼性厌氧,营养要求不高,在血琼脂平板上35℃培养18-24小时,形成较小、圆形、光滑且有狭窄β溶血环的菌落;在液体培养基中呈均匀浑浊生长;因其能生长于4℃的低温环境,故可进行冷增菌;在半固体培养基中,动力自穿刺线向四周蔓延生长,呈倒伞形。
该菌耐碱不耐酸,对热较为敏感,加热至50℃,10分钟可死亡。此外,它还具有耐冷、耐盐的特性,即使在零下20℃的环境中仍然能够生存一年之久。
病例基本情况
患者女,33岁,第一胎孕足月。患者发热 2天,于2024年10月27日下午入住我院产科。患者自述两天前周身发冷,测体温37.4℃,后体温逐渐升高至38.4℃。前一日口服“对乙酰氨基酚
2天,于2024年10月27日下午入住我院产科。患者自述两天前周身发冷,测体温37.4℃,后体温逐渐升高至38.4℃。前一日口服“对乙酰氨基酚 ”“小柴胡颗粒
”“小柴胡颗粒 ”,效果欠佳,仍有间断发热,伴有恶心呕吐,咳嗽
”,效果欠佳,仍有间断发热,伴有恶心呕吐,咳嗽 ,咳少量白痰,无腹痛,无阴道出血及流水。临床考虑“上呼吸道感染”,为进一步诊治收入院。既往于2022年在承德医学院附属医院行TCRP+TCRM。
,咳少量白痰,无腹痛,无阴道出血及流水。临床考虑“上呼吸道感染”,为进一步诊治收入院。既往于2022年在承德医学院附属医院行TCRP+TCRM。
入院查体
宫底高度 34cm、腹围 96cm,宫缩无,胎位 LOA,胎心 140次/分,胎先露已入盆,估计胎儿大小3200克。BP 103/66mmHg,血型B型 RH阳性,心电图 正常范围。
正常范围。
实验室检查
心电图正常范围,生化大致正常,丙肝、梅毒 、艾滋病
、艾滋病 抗体均阴性。
抗体均阴性。
血常规 :白细胞计数WBC 3.8×109/L、中性粒细胞百分数Neut% 72.2%、血红蛋白
:白细胞计数WBC 3.8×109/L、中性粒细胞百分数Neut% 72.2%、血红蛋白 Hb 90g/L、血小板计数PLT 137×109/L、C-反应蛋白
Hb 90g/L、血小板计数PLT 137×109/L、C-反应蛋白 CRP 60.99mg/L。
CRP 60.99mg/L。
目前诊断
1. 宫内孕37周5天,第一胎LOA无产兆;2. 上呼吸道感染;3. 妊娠期中度贫血 。
。
案例经过
10月28日,患者无腹痛,无阴道出血及流水,自觉发热,伴有轻度恶心呕吐,咳嗽,咳少量白痰。查体:T 35.9℃,神清,胎心、胎位正常,离子钾 3.14mmol/L,凝血正常,呼吸道病原体五联卡及流感三联卡检测结果提示:流感病毒A型IgM抗体FLuA-IgM弱阳性、白介素-6IL-6 33.38pg/ml、降钙素 原PCT 0.255ng/ml。
原PCT 0.255ng/ml。
10月29日,患者血培养 报阳,提示革兰阳性杆菌,根据患者情况,考虑菌血症导致,继续抗感染治疗。下午16:10,在腰麻麻醉下行子宫下段剖宫产手术+子宫肌瘤
报阳,提示革兰阳性杆菌,根据患者情况,考虑菌血症导致,继续抗感染治疗。下午16:10,在腰麻麻醉下行子宫下段剖宫产手术+子宫肌瘤 剥除术,以ROA位娩出一女婴,外观发育未见异常,胎盘、胎膜娩出完整。患儿生后鼻塞、偶有吐沫,无体温升高,以“高危儿”收入院,体重 3.19kg,发育正常,营养中等,足月儿外貌,自主体位
剥除术,以ROA位娩出一女婴,外观发育未见异常,胎盘、胎膜娩出完整。患儿生后鼻塞、偶有吐沫,无体温升高,以“高危儿”收入院,体重 3.19kg,发育正常,营养中等,足月儿外貌,自主体位 ,反应良好。
,反应良好。
PCT 0.213ng/ml、白细胞 14.8×109/L、血红蛋白 163g/L、中性粒细胞百分数 69.6%、淋巴细胞百分数 17.9%、C-反应蛋白 0.20ng/ml。出生后抽血培养送检,培养五天未见细菌生长。
10月30日,血培养结果提示产单核李斯特菌,术后继续给予头孢曲松 治疗。药学研究室会诊后建议加用青霉素
治疗。药学研究室会诊后建议加用青霉素 320万单位,每8小时1次静点。
320万单位,每8小时1次静点。
10月31日,产单核李斯特菌药敏结果显示:氨苄西林 敏感、美罗培南
敏感、美罗培南 敏感、红霉素
敏感、红霉素 敏感、青霉素 敏感、复方新诺明 敏感。
敏感、青霉素 敏感、复方新诺明 敏感。
11月8日,术后第十天,患者体温正常,无寒颤及发热,无咳嗽咳痰,子宫复旧良好。复查血培养送检,经全自动血培养仪培养五天后,未见细菌生长。患者及家属要求出院。
血培养实验室检测
该患者10月29日血培养报阳,提示革兰阳性杆菌,接种在血琼脂平板上35℃培养18-24小时,会形成较小、圆形、光滑而有狭窄β溶血环的菌落;在液体培养基中呈均匀浑浊生长;在半固体培养基中,动力自穿刺线向四周蔓延生长,呈倒伞状。
它营养要求不高,在20-25℃环境中培养有动力,穿刺培养2-5天可见倒立伞状生长。肉汤培养物在显微镜下可见翻跟斗运动。该菌的生长范围为2-42℃(也有报道称0℃能缓慢生长),最适培养温度为35-37℃。
10月30日,血培养结果提示产单核李斯特菌。
产单核李斯特菌属于条件致病菌,抵抗力弱者感染后多出现发热、头疼、肌肉酸痛等感冒症状。该患者为产妇,入院前出现感冒等低热症状,在家自行服用药物无效,以“上呼吸道感染”收入院,入院后查感染指标CRP、白介素6、PCT,均有不同程度升高。入院应用头孢曲松抗感染治疗,血培养结果提示产单核李斯特菌。请药学研究室会诊后加用青霉素,患者各项感染指标正常。此病例可排除血培养污染。
产单核李斯特菌为患者感染菌血症的致病菌。此病例中患者就诊及时,发现菌血症及时,行剖宫产手术,胎儿出生未感染。
总结
产单核李斯特菌是一种兼性厌氧细菌,属于李斯特菌属。从形态上看,它是革兰氏阳性短杆菌,大小约为0.4-0.5μm×0.5-2μm,通常呈单个或短链排列,在20-25℃的环境下有鞭毛,能运动,但在37℃时鞭毛数量减少,运动能力也会变弱。
这种细菌的生存能力较强,在自然界中分布广泛,在土壤、水、青贮饲料和动物粪便中都能生存。而且它对环境的耐受性好,能在2-42℃环境中生长,是少数能在冷藏温度下(0-4℃)缓慢生长的细菌之一,这使其在食品保存过程中也能繁殖,带来食品安全隐患。
产单核李斯特菌是一种人畜共患病原菌。它可以通过多种途径感染人类,最主要的是经口感染,即食用被污染的食物,像未经高温消毒的牛奶、软质奶酪、凉拌菜、肉类熟食等。
感染人群中,孕妇、新生儿、老年人和免疫功能低下者症状较为严重,可能引起败血症、脑膜炎和单核细胞增多症。孕妇感染可导致流产、死胎或新生儿感染等严重后果。健康成人感染后可能仅出现轻微发热、头痛 、肌肉痛等类似流感的自限性症状。
、肌肉痛等类似流感的自限性症状。
为了方便全国各地的检验人交流,我们特别成立了检验医学网全国交流群。欢迎您的加入,与大咖对话,分享经验和见解!因微信群超过200人后无法扫码进群,大家可以添加检验医学网编辑个人微信,编辑将邀请您进群。
来源:检验医学网
